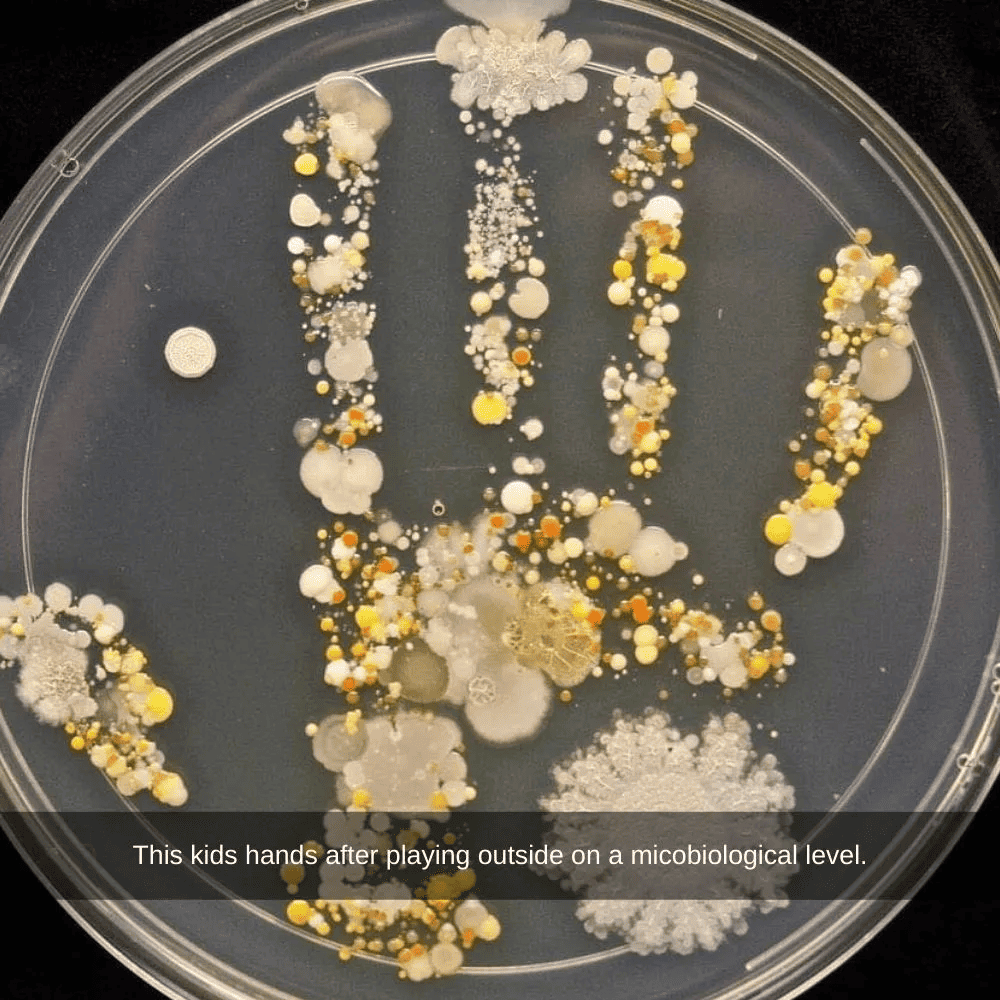

Ewww, the Hidden Microbial World
Childhood lessons often included the sage advice to wash our hands diligently upon returning from outdoor adventures. However, the true necessity of this hygienic ritual may not have been apparent to us back then. If we had been privy to the microscopic reality that unfolds on our hands after playtime in the great outdoors, perhaps we would have been more eager to embrace the suds and water.
This astonishing image unveils the microbial landscape that adorns a child’s hand at a microscopic level. The sight is unsettling, especially considering it captures just one hand’s worth of microbial inhabitants. To contemplate the cumulative effect of this revelation, imagine multiplying it by two—an irrefutable testament to the wisdom of advocating hand sanitizer for every young adventurer.